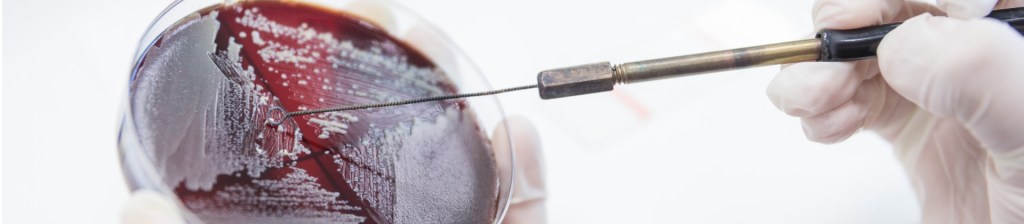
Scientist poking at a red substance in a lab tray

Interest in forensic science careers has never been higher, as advances in technology and a growing justice system increase the demand for skilled professionals. The forensic science discipline comprises multiple career pathways, including both laboratory analysis and field-based investigation. At National University, the Master of Forensic Sciences program reflects this breadth with two specializations: Criminalistics and Investigation.
This blog compares these degree tracks, focusing on the knowledge, skills, interests, and environments inherent to each. With these insights, students will be prepared to make an informed decision between these two distinct but complementary career paths.
Key Takeaways
- Criminalistics and Investigation serve different career paths
- Criminalistics is lab-focused and evidence-driven
- Investigation emphasizes fieldwork and crime scene analysis
- Choosing the right track depends on one’s interests, strengths, and career goals

Understanding National University’s Master of Forensic Sciences
NU’s Forensic Sciences Program and Specializations
In accordance with NIST guidelines, National University’s Master of Forensic Sciences (MFS) program prepares students to apply scientific methods and expertise to real-world crimes and legal investigations. Grounded in areas such as human anatomy, death investigation, and evidence analysis, the program emphasizes the application of laboratory and field techniques to solve complex criminal and civil cases.
MFS students can align their studies with career goals and interests by choosing between two specializations:
- Criminalistics focuses on laboratory analysis such as Forensic Serology and Advanced DNA analysis, trace evidence, and toxicology and more.
- Investigation emphasizes advanced investigative techniques for the field, giving you a comprehensive understanding of the concepts underlying the forensic sciences, scene processing, and casework.
By combining online course formats with an applied, hands-on curriculum, the NU MFS program offers the flexibility for working professionals to gain relevant, real-world forensic experience that fits within the demands of their busy lifestyle.
What is Criminalistics?
Within the field of forensics, criminalistics is the scientific analysis of physical evidence in support of criminal investigations and legal proceedings. It focuses on laboratory-based techniques such as DNA analysis, toxicology, trace evidence examination, and fingerprint identification with an emphasis on accuracy, documentation, and chain of custody. Students develop technical skills needed to collect, process, and interpret evidence, helping to translate scientific findings into clear, defensible conclusions for use in court. Please note, students must have an undergraduate degree in a laboratory science in order to enroll in the MFS with a specialization in criminalistics.
What is Investigation?
Forensic investigation focuses on the systematic collection, documentation, and analysis of evidence in the field to reconstruct events and support legal cases. It emphasizes practical skills such as crime scene processing, evidence handling, fingerprint identification, interviewing, and investigative techniques, integrating scientific principles with real-world applications. Students learn to connect physical evidence with case narratives, working at the intersection between science and law to develop accurate, defensible conclusions.
Core Focus Areas: Lab Science vs. Field Investigation
Criminalistics Focus Areas
DNA Analysis
The science of DNA analysis focuses on the identification and interpretation of genetic material as a powerful form of physical evidence. Students learn the core techniques behind DNA identification, extraction, quantification, amplification, electrophoresis and profile comparison, along with statistical interpretation of results. Emphasis is placed on quality assurance, contamination control, and chain of custody to ensure reliability and the ability to clearly communicate findings in legal contexts.
Toxicology
Toxicology encompasses the detection, identification, and interpretation of drugs, alcohol, and poisons in biological samples. Students learn analytical techniques such as chromatography and mass spectrometry along with principles of pharmacokinetics and drug metabolism. The focus is on accurately determining the presence and concentration of substances, understanding their physiological effects, and interpreting results within medical and legal contexts.
Trace Evidence
The study of trace evidence analyzes small, often microscopic materials such as hair, fibers, soil, glass, gunshot residue, etc. that can link individuals, objects, and locations. Students learn collection and preservation techniques, as well as laboratory methods like microscopy and instrumental analysis to compare and identify materials, help reconstruct events, and establish associations that support investigations and legal conclusions.
Investigation Focus Areas
Crime Scene Analysis
Crime scene analysis involves the systematic recognition, documentation, and preservation of physical evidence at a scene. Students learn techniques in scene security, photography, sketching, evidence collection, and chain of custody, along with methods for reconstructing events based on patterns like bloodstain distribution and material transfer. Studies emphasize accuracy, attention to detail, and adherence to legal and procedural standards to ensure evidence is reliable and admissible in court.
Evidence Collection and Preservation
The study of evidence collection and preservation involves the proper techniques for handling physical, biological, and digital evidence to maintain integrity for investigation and legal proceedings. Students learn methods for identifying, documenting, packaging, and transporting various types of evidence while preventing contamination or degradation. Instruction also covers chain-of-custody protocols, storage requirements, and legal considerations, ensuring that evidence remains reliable, defensible, and admissible in court.
Scene Documentation and Reconstruction
Scene documentation and reconstruction focus on recording techniques such as detailed photography, sketching, 3D mapping, and note-taking combined with analytical methods used to reconstruct action sequences using physical evidence, bloodstain patterns, and environmental context. Emphasis is placed on precision and adherence to legal standards, enabling forensic professionals to present clear, defensible reconstructions in investigative reports and court proceedings.

Skills Development in the Criminalistics Track
Scientific Analysis and Laboratory Techniques
Students learn techniques in DNA profiling, toxicology testing, trace evidence examination, and microscopic comparison to accurately identify and interpret physical evidence.
Quality Control and Attention to Detail
Students develop a variety of skills to ensure that all forensic evidence is accurately analyzed, documented, and maintained according to rigorous OSAC standards.
Data Interpretation and Reporting
Studies focus on expertise in interpreting analytical data and preparing clear, accurate reports that translate complex scientific findings into defensible conclusions.
Understanding of Evidence Admissibility
Students learn to evaluate and handle evidence in accordance with strict legal standards to ensure its admissibility and reliability in court proceedings.
Skills Development in the Investigation Track
Crime Scene Documentation and Processing
Students develop forensic skills and procedures in evidence recording and systematic collection to accurately reconstruct events and support investigative and legal outcomes.
Critical Thinking Under Field Conditions
Studies cultivate critical-thinking capabilities that enable students to assess complex scenes, make evidence-based decisions, and adapt investigative approaches in real-world scenarios.
Evidence Handling and Chain of Custody
Students learn procedures and protocols to ensure that all collected materials are preserved, documented, and legally defensible throughout the investigation process.
Collaboration with Law Enforcement and Legal Professionals
Studies emphasize collaboration and communication skills to effectively share findings and support investigations while ensuring scientific and legal standards are met.

Career Paths and Work Environments
Criminalistics Career Paths
Forensic Laboratory Analyst
Lab analysts conduct scientific testing and analysis of physical evidence, typically working in a controlled laboratory environment to support criminal investigations and provide data for legal proceedings.
DNA Analyst
DNA analysts examine biological samples to extract and compare DNA profiles that identify individuals, working primarily in laboratory settings with occasional collaboration at crime scenes or law enforcement facilities.
Toxicologist
Forensic toxicologists analyze biological samples for drugs, alcohol, poisons, and other substances, working in a lab environment to support investigations, determine causes of impairment or death, and provide evidence for legal cases.
Trace Evidence Examiner
Trace evidence examiners analyze microscopic materials such as hair, fibers, soil, and glass in a lab setting to link people, objects, and locations to criminal activity.
Forensic Investigation Career Paths
Crime Scene Investigator
Crime scene investigators document, collect, and preserve physical evidence at crime scenes, working primarily in the field while collaborating with law enforcement and forensic laboratories.
Medical Examiner Investigator
Medical examiner investigators carry out investigations into unexpected or violent deaths to determine what happened. They often collect evidence, examine bodies and scenes, document findings, and notify family members of the deceased.
Evidence Technician
Forensic evidence technicians process, catalogue, and preserve physical evidence, working in laboratory and evidence storage facilities to maintain integrity and chain of custody for investigations and legal use.
Which Forensic Specialization Fits Your Strengths and Interests?
Consider Criminalistics If You Prefer:
- Laboratory Environments
- Scientific Analysis
- Controlled, Methodical Work
Consider Investigation If You Prefer:
- Fieldwork
- On-Scene Problem-Solving
- Dynamic Environments
How National University Supports Both Forensic Pathways
NU offers both the Criminalistics and Investigation specializations through an applied, practice-based curriculum that emphasizes real-world skill development. Students engage in hands-on learning experiences—from laboratory analysis to crime scene processing—ensuring they build practical skills and competencies for their chosen forensic path.
Designed with working professionals in mind, National University’s flexible course formats and scheduling options allow students to advance their education while balancing other commitments, all while preparing for in-demand forensic roles in either laboratory or field-based settings.
Frequently Asked Questions
Criminalistics focuses on the scientific analysis of physical forensic evidence in a laboratory setting, using techniques such as DNA profiling, toxicology, and trace analysis to identify and interpret materials. In contrast, the Investigation specialization emphasizes field-based work, including crime scene processing, evidence collection and preservation, and event reconstruction to establish a context for evidence.
Yes, criminalistics is a more laboratory-based forensic specialization, focusing on the scientific analysis and interpretation of physical evidence using specialized instruments and controlled procedures. Investigation is field-oriented, emphasizing crime scene processing, evidence collection, and on-site decision-making.
The criminalistics specialization prepares graduates for laboratory-focused careers such as forensic DNA analyst, toxicologist, or trace evidence examiner, supporting legal cases through scientific analysis. The investigation specialization leads to field-based roles like forensic investigator, crime scene investigator, or evidence technician, working at crime scenes with law enforcement to collect, document, and interpret evidence. There are a variety of professional associations that can offer information and guidance on forensic careers and additional training opportunities.
Students may prefer the criminalistics specialization if they’re interested in laboratory-based scientific analysis, working with instruments, and interpreting physical evidence in a controlled environment. Those who prefer fieldwork, hands-on crime scene processing, personal interactions with law enforcement, and dynamic investigative settings should consider the investigation specialization.